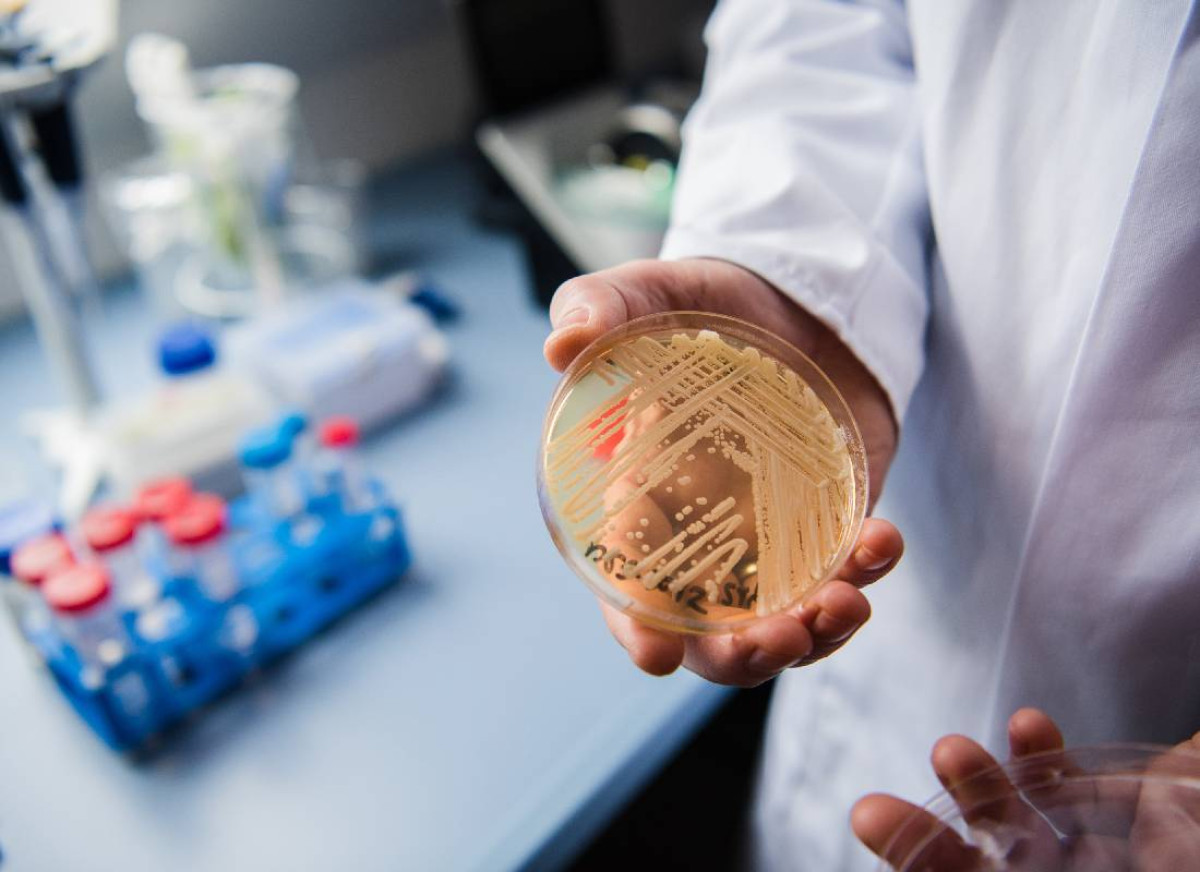

קנדידה אוריס מסוגלת לשרוד על משטחים לפרקי זמן ממושכים, ולהתפשט דרך ציוד רפואי פולשני כגון צנתרים, צינורות הנשמה ועירויים תוך־ורידיים. זנים מסוימים שלה מוגדרים כפתוגנים עמידים במיוחד, משום שהם אינם מגיבים לשלושת סוגי התרופות האנטי־פטרייתיות המרכזיות שבשימוש רפואי. תכונה זו הופכת את הזיהום למסוכן במיוחד במסגרות רפואיות, שבהן מטופלים רבים סובלים ממחלות רקע או ממערכת חיסון מוחלשת.
היקף ההתפשטות מעורר דאגה רחבה. יותר ממחצית ממדינות ארצות הברית דיווחו בשנת 2025 על מקרים קליניים של קנדידה אוריס, והנתונים מצביעים על כך שהפטרייה כבר התבססה כמעט בכל רחבי המדינה. קליפורניה מדורגת במקום השני במספר המקרים המדווחים, עם יותר מ־1,500 נדבקים השנה, אחרי נבדה בלבד. לפי מפת התפשטות שפרסם המרכז לבקרת מחלות, נתונים חסרים נותרו רק לגבי שתי מדינות – אלבמה ופלורידה.
“אם אדם נדבק בפתוגן הזה והוא עמיד לכל טיפול זמין, אין לנו תרופה שנוכל לתת לו כדי להילחם בזיהום. במובן מסוים – הוא נותר לבד,” אמרה מליסה נולאן, פרופסורית־חברה לאפידמיולוגיה וביוסטטיסטיקה באוניברסיטת דרום קרוליינה.
היקף ההתפשטות מעורר דאגה רחבה. יותר ממחצית ממדינות ארצות הברית דיווחו בשנת 2025 על מקרים קליניים של קנדידה אוריס, והנתונים מצביעים על כך שהפטרייה כבר התבססה כמעט בכל רחבי המדינה. קליפורניה מדורגת במקום השני במספר המקרים המדווחים, עם יותר מ־1,500 נדבקים השנה, אחרי נבדה בלבד. לפי מפת התפשטות שפרסם המרכז לבקרת מחלות, נתונים חסרים נותרו רק לגבי שתי מדינות – אלבמה ופלורידה.
אצל אנשים בריאים ייתכן שהגוף יצליח להתמודד עם הזיהום ללא תסמינים חמורים, אך במסגרות בריאותיות הפטרייה עלולה להיות קטלנית. נתונים קודמים של המרכז לבקרת מחלות הצביעו על כך שבין 30 ל־60 אחוזים מהחולים עם זיהום בקנדידה אוריס מתו, אם כי רבים מהם סבלו גם ממחלות קשות נוספות שהגביהו את הסיכון לתמותה.
מחקר שפורסם ביולי האחרון, שהתמקד בעיקר בחולים בנבדה ובפלורידה, מצא כי יותר ממחצית מהנדבקים נזקקו לאשפוז ביחידות טיפול נמרץ, למעלה משליש עברו הנשמה מלאכותית, ויותר ממחציתם נזקקו לעירויי דם. גילם הממוצע של החולים נע בין 60 ל־64, נתון הממחיש את הפגיעות הגבוהה של אוכלוסיות מבוגרות.
מעבר לאיום הרפואי הישיר, מדענים מזהירים כי שינויי האקלים עשויים לשחק תפקיד מפתיע אך משמעותי בהתפשטות הפטרייה. ארתורו קזדוואל, מיקרוביולוג ופרופסור באוניברסיטת ג’ונס הופקינס, הסביר כי באופן היסטורי טמפרטורת הגוף האנושית סיפקה הגנה טבעית מפני רוב הפטריות הסביבתיות. “הטמפרטורה שלנו היא מחסום יעיל מאוד,” אמר, “אבל ככל שהעולם מתחמם, פטריות מסתגלות לטמפרטורות גבוהות יותר. חלק מהן עשויות לעבור את מה שאני מכנה ‘מחסום הטמפרטורה’ – ולהיות מסוגלות לשרוד בתוך גוף האדם.”
הסכנה שמציבה קנדידה אוריס נובעת משילוב נדיר של תכונות: עמידות קיצונית לתרופות, קושי באבחון ללא בדיקות מעבדה ייעודיות, יכולת הישרדות על משטחים וציוד רפואי, ופגיעה בעיקר באוכלוסיות החלשות ביותר – חולים קשים, קשישים ובעלי מערכת חיסון מוחלשת. כל אלה הופכים את הפטרייה לאתגר משמעותי במיוחד עבור מערכות בריאות שכבר מתמודדות עם מחסור בכוח אדם ובלחץ תקציבי.
בתי חולים ומתקנים רפואיים מנסים לבלום את ההתפשטות באמצעות פרוטוקולי ניקוי ובידוד מחמירים, אך המשימה מורכבת. המרכז לבקרת מחלות ממליץ לזהות מוקדם חולים בסיכון גבוה, להחיל אמצעי זהירות במגע עם חולים נגועים, לחטא ביסודיות ציוד ואזורי אשפוז, ולוודא העברת מידע בין מתקנים רפואיים כאשר חולה נגוע מועבר ממקום למקום.
התפשטותה של קנדידה אוריס משקפת איום רחב יותר בעידן המודרני: עלייה במספר פתוגנים עמידים לתרופות, במקביל לשינויים סביבתיים גלובליים. ככל שהטמפרטורות העולמיות ממשיכות לעלות, מומחים מזהירים כי פטריות וגורמי מחלה נוספים עלולים להסתגל לתנאים חדשים ולחדור לגוף האדם ביתר קלות.
בינתיים, המרוץ נגד הזמן נמשך. מדענים מנסים לפתח טיפולים חדשים, ומערכות הבריאות פועלות לצמצם את מוקדי ההתפרצות – במאבק שממחיש עד כמה שביר האיזון בין הרפואה המודרנית לבין עולם פתוגנים שממשיך להשתנות ולהסתגל.





















